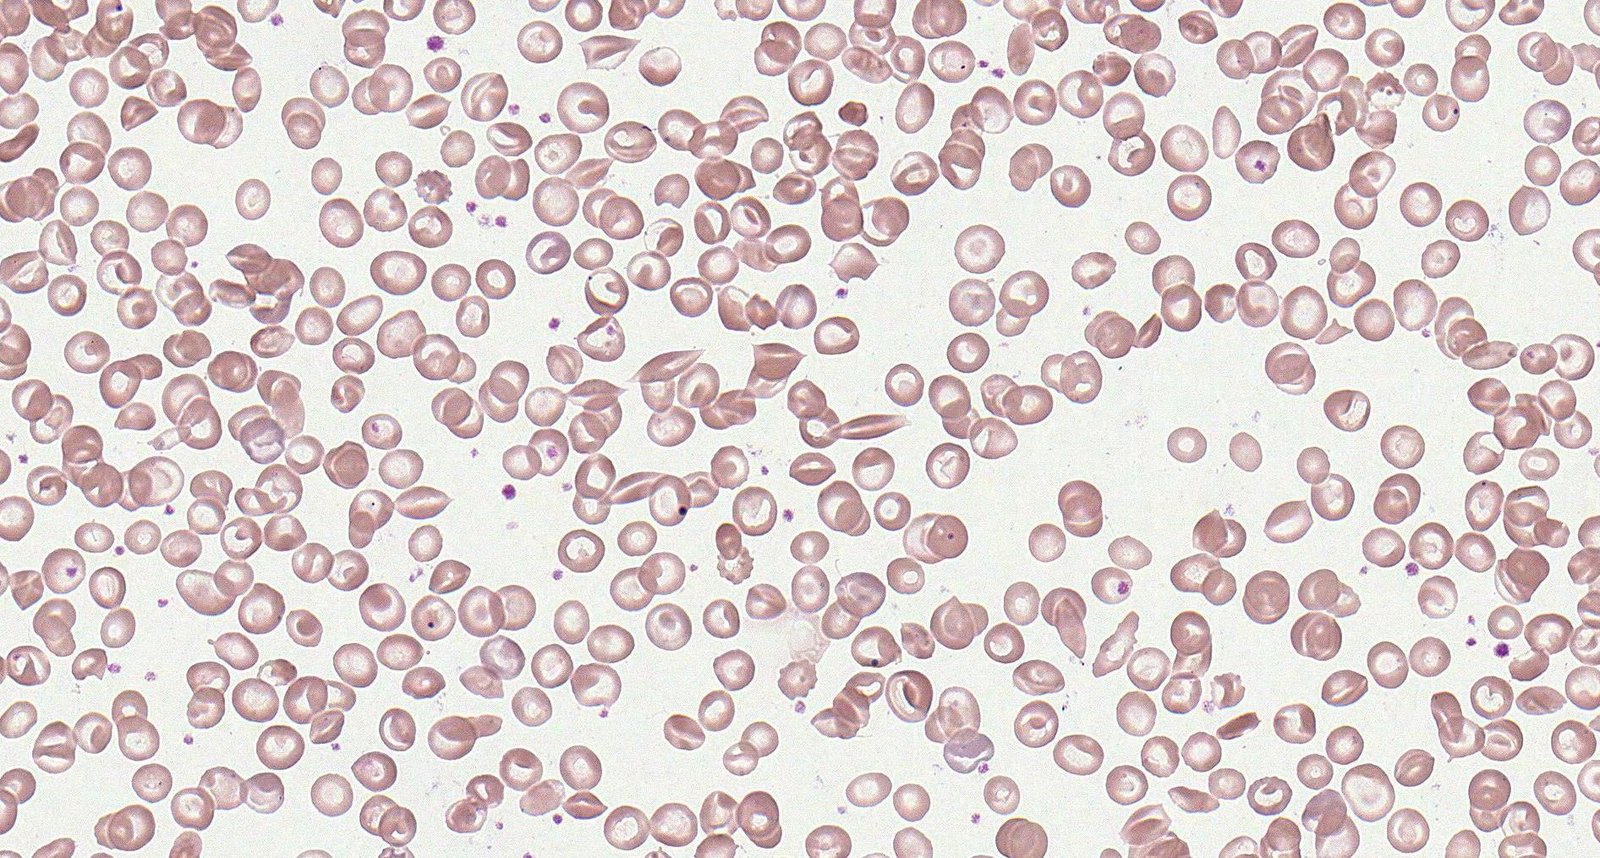

Sickle cell disease is caused by hereditary hemoglobinopathy, which includes sickle cell anemias (i.e., HbSS and HbSβ0thal) and other compound heterozygous genotypes (e.g., HbSC, HbSβ+thal). Mutations in the hemoglobin β chain lead to the formation of hemoglobin S, which polymerizes when deoxygenated. Deoxygenated HbS results in sickle-shaped erythrocytes that can occlude blood vessels and cause ischemia. Homozygous sickle cell anemia (HbSS) is the most common variant of sickle cell disease and occurs predominantly in individuals of African and Eastern Mediterranean descent, although people of any ethnicity can develop sickle cell disease. Screening for sickle cell disease is routinely recommended for all infants born in the United States. Hemoglobin separation studies (e.g., hemoglobin electrophoresis, high-performance liquid chromatography) and genetic studies are used to confirm the diagnosis. Complications can begin in early infancy and childhood and continue for the rest of the affected individual's lifetime. Acute complications include vascular occlusion events (e.g., vasoocclusive pain crisis, stroke, acute chest syndrome), severe anemia (e.g., sequestration, aplastic anemia), and invasive infections from encapsulated organisms (e.g., bacteremia, pneumonia, meningitis, osteomyelitis). Infants with confirmed sickle cell disease should receive antibiotic prophylaxis against invasive pneumococcal infection and all age-appropriate immunizations, and hydroxyurea therapy. Transfusion therapy (e.g., for vasoocclusive events, secondary prevention of stroke) and hydroxyurea are key aspects of decreasing morbidity and mortality. Screening for complications of sickle cell disease (including annual transcranial Doppler to screen for stroke risk from 2–16 years of age) should occur at regular intervals. Long-term complications include progressive loss of organ function (e.g., functional asplenia, cognitive decline, avascular osteonecrosis) secondary to repeated infarctions. Allogeneic bone marrow transplantation is currently the only curative treatment option.
Sickle cell trait, which occurs in heterozygous carriers (HbSA), is not considered a form of sickle cell disease, but affected individuals can experience acute complications due to sickling under certain conditions, for example during high-intensity exercise or at high altitude.
-
Sickle cell disease
- A group of conditions characterized by mutations in the HbS genotype that result in phenotypic manifestations similar to sickle cell anemia
- Genotypes include HbSS, HbSβ0thal, HbSβ+thal, HbSC, and rarely, HbSD, and HbSE.
- Symptoms range from mild to severe
-
Sickle cell anemia [1]
- The most severe clinical presentation of sickle cell disease
- Genotypes include homozygous HbSS and compound heterozygous HbSβ0thal (a form of sickle beta thalassemia).
-
Sickle cell trait [2]
- Refers to the sickle cell carrier genotype (HbAS)
- Not considered a form of sickle cell disease
- Complications occur rarely (see “Clinical features”).
Sickle cell anemia genotypes (i.e., HbSS and HbSβ0thal) have the most severe clinical presentations and have almost identical clinical manifestations. [1]
- Predominantly affects individuals of African and Eastern Mediterranean descent [3]
- Africa has the highest prevalence of the disease (30% heterozygoteprevalence).
- HbS gene is carried by 8% of the African American population. [4]
- Sickle cell anemia is the most common form of intrinsic hemolytic anemia worldwide.
Epidemiological data refers to the US, unless otherwise specified.
Genetics
-
Point mutation in the β-globingene(chromosome 11) →glutamic acid replaced with valine (single amino acid substitution) → 2 α-globin and 2 mutatedβ-globin subunits create pathological hemoglobin S(HbS).
- Heterozygotes (HbAS): carry one sickle allele and one other (usually normal) → sickle cell trait
- Homozygotes (HbSS): carry two sickle alleles → sickle cell anemia
-
Glutamic acid can also be replaced with a lysine, creating hemoglobin C
- Heterozygosity for hemoglobin S and hemoglobin C; → hemoglobin SC disease→ phenotype more severe than sickle cell trait but not as severe as sickle cell disease (e.g., fewer acute sickling events)
- Homozygotes (HbCC) → hemoglobin C disease
- Heterozygotes (HbAC) → hemoglobin C trait
Hemoglobin composition
For details on hemoglobin and its variants, see “Hemoglobin synthesis” and “Hemoglobin variants” in the article “Erythrocyte morphology and hemoglobin.”
| Hemoglobin | Globin chains | Sickle cells | Hemoglobin C | |||
|---|---|---|---|---|---|---|
| Sickle cell trait | Sickle cell disease | Hemoglobin SC disease (HbSC) | Hb C carrier | Hb C disease | ||
| HbA | ααββ | ↓ | Absent | Absent | ↓ | Absent |
| HbA2 | ααδδ | Normal | Normal | ↓ | ↓ | Absent |
| HbF | ααγγ | Normal | ↑ | Normal | Normal | Normal |
| HbH | ββββ | Absent | Absent | Absent | Absent | Absent |
| HbS | ααββ | ↑ | ↑↑ | ↑ | Absent | Absent |
| HbC | ααββ | Absent | Absent | ↑ | ↑ | ↑↑ |
Pathophysiology
-
HbS polymerizes when deoxygenated, causing deformation of erythrocytes (“sickling”). This can be triggered by any event associated with reduced oxygen tension.
-
Hypoxia (e.g., at high altitudes)
- In homozygotes, up to 100% of the hemoglobin molecules are affected, leading to sickle cell formation under minimally decreased oxygen tension.
- In heterozygotes, sickling only occurs due to severe reduction in oxygen tension.
- Infections
- Dehydration
- Acidosis
- Sudden changes in temperature
- Stress
- Pregnancy
-
Hypoxia (e.g., at high altitudes)
- Sickle cells lack elasticity and adhere to vascular endothelium, which disrupts microcirculation and causes vascular occlusion and subsequent tissue infarction.
- Extravascular hemolysis; and intravascular hemolysis are common and result in anemia.
- Hemolysis and the subsequent increased turnover of erythrocytes may increase the demand for folate, causing folate deficiency.
- The body increases the production of fetal hemoglobin (HbF) to compensate for low levels of HbA in sickle cell disease.
Sickle cell trait
- Often asymptomatic
- Painless gross hematuria due to renal papillary necrosis: often the only symptom
- Hyposthenuria: nocturia, enuresis
- Recurrent urinary tract infections
- Renal medullary carcinoma
- Symptoms of sickle cell disease may manifest due to severe oxygen deficiency.
- Exertional collapse and sudden death can occur during or after extreme physical exertion (e.g., during sports, military training). [5]
Sickle cell disease

Onset
- ∼ 30% develop symptoms in the first year of life; > 90% by age 6 years
- Typically manifests after 3–6 months of age as the production of HbF decreases and HbS levels increase [6]
Acute manifestations
-
Vaso-occlusive events
-
Dactylitis in children< 5 yearsof age ; [6]
- Typically the earliest manifestation of sickle cell disease
- Most common in children between 6 months and 2 years of age; uncommon in older children and adults
-
Vasoocclusive crises (sickle cell pain crisis) [1][7]
- Most common acute complication of sickle cell disease
- Characterized by recurrent episodes of severe throbbing or sharp pain
- Typically affects the limbs, chest, and back and lasts for ∼ 7 days
- Often associated with other vasoocclusive events (especially dactylitis in children)
- Acute chest syndrome
- Priapism
- Stroke (common in children)
- Sickle cell hepatopathy
- Organ infarctions (any organ; particularly the spleen)
- Avascular necrosis
-
Dactylitis in children< 5 yearsof age ; [6]
-
Infection
- Pneumonia
- Meningitis
- Osteomyelitis; (most common cause: Salmonella spp., Staphylococcus aureus)
- Sepsis; (most common cause: Streptococcus pneumoniae)
-
Acute hemolytic crisis
- Splenic sequestration
- Aplastic crisis

Chronic manifestations
- Chronic hemolytic anemia: fatigue, weakness, pallor; usually well-tolerated
- Chronic pain
- Cholelithiasis (pigmented stones)
Symptoms of other forms of sickle cell syndrome (HbSC disease and HbS/beta-thalassemia) are similar to sickle cell disease but less severe.
| Screening for sickle cell disease [8][9][10] | ||
|---|---|---|
| Indications | Recommended test | |
| Prenatal screening [1] |
|
|
| Neonatal screening [11] |
|
|
| Older infants/ children/adult screening |
|
|
Sickling tests and solubility tests should not be used to screen patients for sickle cell disease as they cannot distinguish between sickle cell trait and sickle cell disease, nor can they detect other abnormal hemoglobinopathies [12]
As adult hemoglobin levels may be very low or absent in extremely premature infants, premature neonates with sickle cell trait may have a false-positive screening result for sickle cell disease. [11][13]
General principles
- Sickle cell trait and/or disease is most commonly diagnosed on routine neonatal screening.
- Confirmatory studies should be performed for all individuals with a positive or inconclusive result on initial screening.
- Additional laboratory studies (CBC with MCV and reticulocyte count) and imaging are not required to confirm the diagnosis but may show characteristic changes.
Confirmatory studies [9][11]
- Use a different modality than the initial screening test. [6][10]
- Perform confirmatory studies within the first 2 months of age for infants with a positive or inconclusive result on sickle cell disease screening. [1][11]
Qualitative analysis
-
Modalities
- Hemoglobin electrophoresis
- Isoelectric focusing
-
Findings
- No sickle cell trait/disease: hemoglobin A and F only
-
Sickle cell trait/disease:
- Hemoglobin S is also present.
-
Additional hemoglobin types may also be found in heterozygoussickle cell disease, e.g.:
- Hemoglobin C in hemoglobin SC disease
- Hemoglobin D in hemoglobin SD
- Hemoglobin E in hemoglobin SE
On hemoglobin electrophoresis, HbA migrates the fastest (the greatest distance) towards the anode, followed by HbF, HbS, and HbC (i.e., HbA> HbF> HbS> HbC).

Quantitative analysis
-
Modalities
- High performance liquid chromatography
- Capillary electrophoresis
| Quantitative analysis of hemoglobin types | |||
|---|---|---|---|
| Hemoglobin | Normal | Sickle cell trait | Sickle cell disease |
| HbA | 95–98% | 60% | 0% |
| HbS | 0% | 40% | 75–95% |
| HbF | < 2% | < 2% | 5–25% |
DNA studies
- Consider (in consultation with specialists) when Hb electrophoresis and/or chromatography cannot differentiate between hemoglobinopathies (e.g., HbSS and HbSβ0thal).
- For further information on hemoglobin composition and genetics of sickle cell disease, see “Pathophysiology.”
Additional studies [8]
Laboratory studies
-
CBC
- Mild-to-severe anemia with reticulocytosis
- Elevated neutrophils and platelets
-
Peripheral blood smear findings may include:
- Crescent-shaped sickled RBCs; (drepanocytes or sickle cells)
- Target cells
- Howell-Jolly bodies: occur with splenic dysfunction
- Reticulocytosis: indicates the presence of hemolysis
- Diagnostic studies for hemolytic anemia: frequently positive

Skull x-ray [14]
- May show hair-on-end (“crew cut”) sign
- Caused by periosteal reaction to erythropoietic bone marrow hyperplasia

Hair-on-end appearance on skull x-ray may also be present in patients with thalassemia.
Patients with sickle cell disease should ideally be managed in comprehensive sickle cell disease centers. Management of patients who do not have easy access to such specialized centers should be done in frequent consultation with hematologists or sickle cell experts. [15]
Overview [1][16]
-
Infants and children
- Immunizations
- Antibiotic prophylaxis against invasive pneumococcal disease until 5 years of age
- Hydroxyurea therapy regardless of clinical severity to minimize disease-related complications
- Annual transcranial Doppler to screen for stroke risk from 2–16 years of age
- Regular monitoring for other common complications of sickle cell disease
-
Adults
- Immunizations
- Hydroxyurea therapy if clinically indicated
- Reproduction counseling and contraception
- Regular monitoring for complications of sickle cell disease
-
Educate all patients or caregivers on: [16]
- Signs and symptoms of complications of sickle cell disease
- Importance of attending regular screenings
- How to seek specialist medical advice
- Treatment options (e.g., hydroxyurea, HSCT)
Infection prevention [1]
- Immunizations
- Patients should receive all vaccines recommended for their age.
- Pneumococcal vaccines and meningococcal vaccines are particularly important; earlier/additional doses may be required. [1]
-
Antibiotic prophylaxis against invasive pneumococcal disease
-
Daily prophylactic penicillin [1]
- Recommended from early infancy (1–2 months of age) until 5 years of age for children with HbSS . [1][6]
- Continue penicillin prophylaxis in children who have had a splenectomy or history of invasive pneumococcal infection.
- Erythromycin prophylaxis is suitable for children with penicillin allergy. [17][18]
-
Daily prophylactic penicillin [1]
- Educate patients/caregivers to seek immediate medical attention if fever > 38.5°C (101.3°F) occurs.
Initiate early antibiotic prophylaxis and ensure appropriate immunizations in all infants confirmed to have sickle cell disease to minimize the risk of serious infections. [1][11]
Prevention of vasoocclusive crises and anemia [1][16]
The following pharmacologic interventions and avoidance of known triggers (e.g., dehydration, high altitudes) are the main aspects of preventing complications of sickle cell disease.
Hydroxyurea therapy
- First-line agent: hydroxyurea [1][16]
- Hydroxyurea reduces the incidence of acute painful episodes and improves survival.
Indications [1][16]
- All infants> 9 months, children, and adolescents with sickle cell anemia regardless of symptom severity
- Adults with any of the following:
- Frequent (≥ 3 episodes/year) acute pain episodes or other vasoocclusive events
- Regular pain that interferes with activities of daily living and quality of life.
- Severe symptomatic anemia
- History of severe and/or recurrent acute chest syndrome
Mechanism of action
Stimulation of erythropoiesis and increased fetal hemoglobin → proportional reduction of sickled hemoglobin → decreased red blood cell polymerization → fewer vasoocclusive episodes
Monitoring [1]
- Monitor CBC and reticulocytes every 4 weeks during dose titration.
- Increase dose only if cell counts are in an acceptable range.
- If neutropenia or thrombocytopenia occurs:
- Withhold hydroxyurea temporarily.
- Monitor CBC until counts increase.
- Restart hydroxyurea at a dose 5 mg/kg/day lower than the previous dose.
- Once on a stable dose, monitor HbF concentration, CBC, reticulocyte count every 3 months.
Possible adverse effects
- Darkening of skin and nailbeds
- Myelosuppression
- Macrocytic anemia with megaloblastic or nonmegaloblastic features
Important considerations [1][16]
- The safety of hydroxyurea therapy during pregnancy and breastfeeding has not been established. [1][19]
- Perform a pregnancy test before initiating hydroxyurea therapy.
- Counsel patients (both male and female) on the need for contraception during hydroxyurea therapy.
- Clinical response to hydroxyurea may be seen only after 3–6 months of therapy.
- Educate patients on the importance of treatment adherence.
- Failure to respond to therapy (after at least 6 months of hydroxyurea therapy at the maximum tolerated dose): Refer to a sickle cell expert.
Novel therapies for sickle cell disease [16]
Hydroxyurea and chronic blood transfusions are the most established therapies for sickle cell disease. Recently approved agents include the following.
- Oral L-glutamine: for children ≥ 5 years of age [16][20]
- Crizanlizumab: for patients ≥ 16 years of age with a history of vasoocclusive crises [21][22]
-
Gene therapy: for patients ≥ 12 years of age with recurrent vasocclusive crises [23]
- Exagamglogene autotemcel
- Lovotibeglogene autotemcel
Allogeneic bone marrow transplantation (allogeneic HSCT) [24]
-
Overview
- Currently the only potentially curative option
- Associated with better outcomes if performed at a younger age (< 16 years)
- However, there is a paucity of evidence on the overall benefit of allogeneic HSCT in patients with sickle cell disease.
-
Indications
- Genotype associated with sickle cell anemia (e.g., HbSS, Hbβ0-thal)
-
Presence of complications, e.g.:
- History of overt stroke or abnormal transcranial Doppler
- Recurrent episodes of pain and/or ACS episodes that are unresponsive to chronic transfusions, hydroxyurea, or novel therapies
- Donor choice: HLA-matched related donors are preferred over nonrelated donors.
Screening for complications
Individuals with sickle cell disease are at risk for hemolysis due to shortened RBC lifespans and end-organ damage from repeated infarcts secondary to sickling.
| Screening for complications of sickle cell disease [1][16] | ||
|---|---|---|
| Studies and further management | ||
| Stroke risk [1][16][25][26] |
|
|
| Hemolysis [16] |
|
|
| Impaired renal function [1][16] |
|
|
| Hepatobiliary disease [1] |
|
|
| Pulmonary hypertension and diastolic dysfunction [16] |
|
|
| Respiratory disease [1][16] |
|
|
| Retinopathy [1] |
|
|
| Bone disease [16] |
|
|
| Transfusional iron overload |
|
|
Management of chronic pain [1]
- Pain lasting > 3 months is considered chronic.
- Etiology is often nonspecific; maybe due to avascular necrosis or neuropathy
- Tailor management to the individual.
- Analgesic options include NSAIDs, opioids, adjuvant analgesics (e.g., antidepressants, anticonvulsants), and adjunctive nonpharmacological therapies (e.g., acupuncture, massage therapy, cognitive interventions).
General principles [1][29]
-
Mechanism of action
- Transfusion of normal (HbA) erythrocytes decreases the percentage of HbS erythrocytes.
- Achieved by diluting (simple transfusion) or replacing (exchange transfusion) patient's HbS erythrocytes with donor HbA erythrocytes
-
Main indications
- Exchange transfusions are preferred for the prevention and treatment of vasoocclusive events (e.g., severe acute chest syndrome, stroke, multisystem organ failure).
- Simple transfusions are preferred for the management of acute anemia in sickle cell disease.
-
Important pre-transfusion considerations to minimize risk of alloimmunization and transfusion reactions:
- In addition to ABO typing and Rh matching, consider extended RBC phenotype matching before the first transfusion. [29]
- Leukoreduced packed red blood cell (pRBC) units are preferred. [1]
-
Monitoring
- Quantitative hemoglobin studies can track improvements in hemoglobin S percentages before and after transfusions.
- Monitor patients on chronic transfusion therapy for complications, such as, iron overload, alloimmunization, autoimmunization, and delayed transfusion reactions (see “Transfusion reactions” for details). [29]
Transfusions of uncrossmatched or type-specific blood can be given to patients with severe anemia causing hemodynamic compromise or shock. Do not delay transfusion in these patients while awaiting results of recommended pRBC matching criteria. [31]
Patients with sickle cell disease should ideally receive pRBC transfusions that are matched for C, E, and K antigens. Perform extended RBC phenotype matching when possible. [1][29]
Simple transfusions and exchange transfusions [1][29]
Both simple transfusion and exchange transfusion are used in the management of sickle cell disease depending on availability and indication.
| Simple transfusions versus exchange transfusions [1][29] | ||
|---|---|---|
| Simple transfusions | Exchange transfusions | |
| Definition |
|
|
| Advantages |
|
|
| Disadvantages |
|
|
| Target Hb levels |
|
|
Unless directed by a sickle cell expert, avoid transfusing to Hb > 10 g/dL (unless HbS percentage is already low) because doing so increases the risk of hyperviscosity and vasoocclusive events. [1][16]
Indications for transfusion in sickle cell disease
| Conditions necessitating pRBC transfusion in sickle cell disease [1][29][32] | |||
|---|---|---|---|
| Indications for transfusion | Preferred type of transfusion [1] | ||
|
Acute indications (Acute transfusion therapy) |
Vasoocclusive events |
|
|
|
|
||
| Anemia |
|
|
|
| Long-term prevention (Chronic transfusion therapy) |
|
|
|
| Prophylactic transfusion |
|
|
|
Sickle cell disease is associated with multiple acute complications, which require timely recognition and management to decrease morbidity and mortality. The most common categories of complications are vasoocclusive crises, other vasoocclusive events, infection, and severe anemia. [1][7][33]
- ABCDE approach
- Start supplemental O2 if SpO2 is < 95%.
- Administer analgesics.
- Order diagnostics as needed (e.g., CBC, reticulocyte count, CMP, liver chemistries, chest x-ray, blood cultures).
- Use IV fluids judiciously; overhydration can trigger or worsen acute chest syndrome. [1][6][34]
- Consult hematology urgently.
- Assess the need for transfusion; see “Indications for transfusion in sickle cell disease.”
- Manage the underlying event; see “Acute complications of sickle cell disease” for possible etiologies.
Approach [1][33]
- Provide prompt and proactive pain management.
- Address modifiable causes of erythrocyte sickling (e.g., dehydration, hypoxia).
-
Ensure adequate hydration.
- Encourage oral hydration, consider antiemetics if not tolerated.
- Assess for indications for IV fluids. [1][33]
- Clinical features of dehydration and hypovolemia: Consider IV normal saline boluses. [33]
- Euvolemic patient who is unable to drink: IV fluids no higher than the maintenance fluid rate.
- Administer supplemental oxygen if SpO2 on room air is < 95%. [1]
-
Ensure adequate hydration.
- Consider diagnostics for:
- Evaluation of known triggers (e.g., dehydration, infection) or complications (e.g., end-organ damage)
- Exclusion of differential diagnoses in patients with atypical features:
- Evaluate for acute chest syndrome in patients with prominent chest pain.
- Evaluate for infection in febrile patients.
- Patients requiring admission
- Consult hematology.
- Reassess pain levels every 30–60 minutes and titrate analgesic dose as needed.
Patients with sickle cell disease often face bias when seeking emergent medical management for pain. Believe the patient's pain and remember that sickle cell disease can occur in patients of all ethnicities. [33]
Symptoms of vasoocclusive crisis can overlap with other complications (e.g., acute chest syndrome, stroke, infection). If there is clinical uncertainty, initiate a diagnostic workup and seek specialist advice immediately. [1]
Overhydration can trigger acute chest syndrome; administer IV fluids judiciously. [34]
Pain management [1][33][35]
- Management should be guided by patient-reported pain severity.
- Consider alternative diagnoses (e.g., acute chest syndrome, acute MI, septic arthritis) if pain is atypical.
Analgesics [1][33]
- Use individualized (preferred) or sickle cell-specific pain management protocols.
- Parenteral opioids (morphine or hydromorphone) are preferred for moderate to severe pain crises.
- Administer first dose within 30–60 minutes of arrival.
- If an IV cannot be established quickly, administer subcutaneously or intranasally.
-
Opioid-tolerant patients
- Patients on long-acting oral opioids: Continue the home dose.
- Patients on short-acting opioids: Convert current total daily dose to IV equivalent dose.
- Opioid-naive patients: Follow doses recommended in “Parenteral analgesia.”
- Consider adjunctive NSAIDs for 5–7 days if there are no contraindications to NSAIDs. [33]
Reassessment and disposition
- Titrate medications to effect.
- Reevaluate pain every 15–30 minutes until well controlled.
- Consider incremental dose escalations of 25% for uncontrolled pain. [1]
- Consider adjunctive nonpharmacological modalities [33]
- Uncontrolled pain after 6–8 hours [1]
- Admit the patient.
- Consider patient-controlled analgesia (PCA).
- Consider consulting pain management services for adjuvant therapies. [33]
If possible, consider starting PCA dosing in the emergency room to prevent delays in pain control. [1]
Avoid steroids for pain crisis (unless indicated for another condition, e.g., asthma) because steroid use is associated with complications, including rebound pain. [33]
Further management [1][33]
-
Monitoring
- Frequently assess the patient with objective pain and sedation scales. [1]
- Admitted patients
- Monitor CBC and reticulocyte count until clinical improvement.
- Monitor SpO2 when administering around-the-clock opioid analgesia. [1][36]
-
Secondary prevention
- Encourage incentive spirometry every 2–4 hours while awake and early ambulation to prevent atelectasis and acute chest syndrome. [1]
- Encourage fluid and recommended fiber intake and consider stool softeners or laxatives to prevent opioid-induced constipation.
- Manage opioid-induced pruritus with oral antihistamines every 4–6 hours e.g., diphenhydramine. [1][37]
An acute drop in hemoglobin concentration may indicate the development of acute chest syndrome and/or multisystem organ failure (MSOF), which can affect the lungs, liver, and/or kidneys. MSOF most commonly manifests when the pain crisis begins to improve. [1][34]
Patients who require > 3 hospitalizations for vasoocclusive crises in a year have an increased risk of mortality. Consider starting this group of patients on hydroxyurea therapy. [1]
Stroke [1][25]
-
Clinical presentation
- Sudden onset of focal neurologic deficits
- Altered mental status, seizures
- Severe headache, nausea, vomiting
- Possible history of moyamoya disease, silent strokes (cognitive decline), TIAs
- Diagnostics: See “Diagnosis of stroke.”
-
Acute management (of patients with acute neurological deficits, including TIA)
- Activate the stroke team.
- Administer simple or exchange transfusion within two hours of symptom onset. [25]
- Consider reperfusion therapy for ischemic stroke within 4.5 hours of symptom onset. [25]
- Admit to ICU.
- See also “Acute management checklist for ischemic stroke.”
- Long-term management: See “Secondary stroke prevention in sickle cell disease” for details.
Stroke (silent or overt) is a common complication of sickle cell disease. Early detection and management are essential to prevent or minimize cognitive decline. [1][25]
Acute chest syndrome [1][34]
- Clinical features and diagnosis: See “Diagnostic criteria for acute chest syndrome.”
- Management: See “Management of acute chest syndrome.”
Acute chest syndrome is the most common cause of mortality in patients with sickle cell disease. It may be preceded or accompanied by a vasoocclusive pain crisis. The presence of a new pulmonary infiltrate on imaging is diagnostic of acute chest syndrome. [1]
Splenic sequestration [1]
- Pathophysiology: splenic vasoocclusion and entrapment and pooling of large amounts of blood in the spleen
-
Clinical presentation
- Most commonly affects children < 5 years of age
- Acute left upper quadrantpain, splenomegaly
- Hypotension and/or hypovolemic shock, especially in infants
- Symptoms of anemia (e.g., pallor, fatigue)
-
Supportive findings
- Anemia (Hb drop of ≥ 2 g/dL) with reticulocytosis
- Thrombocytopenia
-
Acute management
- Immediate IV fluid resuscitation for hypovolemia
- Simple RBCtransfusion in consultation with a sickle cell expert (avoid raising hemoglobin> 8 g/dL)
-
Long-term management
- Patients/caregivers should be taught to monitor spleen size to detect recurrence early.
- Splenectomy or partial splenectomy may be indicated (e.g., for hypersplenism or life-threatening or recurrent sequestration events) [1]
Splenic sequestration is uncommon in older patients with HbSS due to splenic atrophy from repeated splenic infarctions. Patients with HbSC and HbSβ+thal may have splenic sequestration into adulthood. [1]
Acute sickle cell hepatopathy [1][38]
-
Acute sickle hepatic crisis: hepatic ischemia during a vasoocclusive crisis
- Symptoms: fever, acute onset RUQ pain, jaundice, tender hepatomegaly
- Laboratory findings: transaminitis, conjugated hyperbilirubinemia
- Management
- Supportive therapy for the vasoocclusive episode
- Monitor patient closely for progression to more severe sickle cell hepatopathy.
-
Acute hepatic sequestration: hepatic ischemia and sequestration of blood during a vasoocclusive crisis
- Symptoms: acute RUQ pain, hepatomegaly, acute anemia
- Laboratory findings: normal transaminases, conjugated hyperbilirubinemia, ↑ ALP
- Management: simple or exchange transfusion
-
Acute intrahepatic cholestasis: a life-threatening form of sickle cell hepatopathy
- Symptoms: fever, RUQ pain; can rapidly progress to acute liver failure
- Laboratory findings: transaminitis, mixed hyperbilirubinemia, ↑ ALP, coagulopathy
- Imaging: no evidence of biliary obstruction
- Management
- Exchange transfusion
- Supportive management of liver failure and/or coagulopathy
Suspect life-threatening acute intrahepatic cholestasis when laboratory studies suggest a cholestatic jaundice picture but imaging does not identify common bile duct obstruction or cholangitis. [1]
Venoocclusive priapism [1]
- A common complication of sickle cell disease
- Should be identified and managed promptly to minimize the risk of impotence
- See “Low-flow priapism” for details.
Acute anemia in sickle cell disease is defined as a drop in hemoglobin of ≥ 2.0 g/dL from baseline, or a hemoglobin value < 6 g/dL (if baseline is unknown). [1]
Baseline hemoglobin values are typically 6–8 g/dL for HbSS, 9–12 g/dL for HbSβ+ thal, and 10–15 g/dL for HbSC. [1]
Approach
- Stabilize the patient and provide immediate hemodynamic support, if needed.
- Send an urgent type and screen and crossmatch.
- Administer blood transfusion according to transfusion indications in sickle cell disease.
- Identify and treat the underlying cause.
Possible etiologies of acute anemia include aplastic crisis, splenic sequestration, acute hepatic sequestration, acute chest syndrome, delayed hemolytic transfusion reaction, infection, sepsis, and acute blood loss (not necessarily linked to sickle cell disease). [1]
Aplastic crisis [1]
-
Pathophysiology
- Red blood cell aplasia with an acute, severe drop in hemoglobin and associated reticulocytopenia due to an infection with parvovirus B19
- Dysmorphic erythrocytes in sickle cell disease and hereditary spherocytosis are susceptible to parvovirus B19 infection, which can temporarily suppress bone marrow erythropoiesis.
-
Clinical presentation
- Fever, pallor
- Fatigue, lethargy, dyspnea
- Syncope
- Heart failure (rare)
-
Supportive findings
-
CBC shows pancytopenia.
- Hemoglobin is typically ∼3–6 g/dL.
- Reticulocytopenia (reticulocytes can be zero)
- Parvovirus B19 is typically positive.
-
CBC shows pancytopenia.
-
Management
- Immediate simple RBC transfusion
- Monitor for resolution.
- Infection control measures, e.g., droplet precautions to prevent spread of parvovirus B19
General principles [1]
- Patients with sickle cell disease are at high risk of infection most commonly by encapsulated bacteria due to functional asplenia.
- Risk of infection, septicemia, and meningitis is highest during infancy and early childhood.
- Immunizations and antibiotic prophylaxis are important aspects of sickle cell disease management: See “Infection prevention” in “Long-term management of sickle cell disease.”
- Patients with symptoms of infection should receive aggressive antibiotic therapy.
Fever (≥ 38.5°C, ≥ 101.3°F) in sickle cell disease may be due to vasoocclusive crisis, life-threatening complications (e.g., acute chest syndrome), or infection (which can rapidly progress to septicemia) and requires urgent management. [1]
Routine diagnostics [1]
- CBC
- Reticulocyte count
- Blood cultures
- Liver chemistries and renal function test
- Chest x-ray if there is chest pain, cough, or tachypnea
- Consider urinalysis, urine culture, CSF analysis, or synovial fluid analysis depending on underlying symptoms.
Do not delay empiric antibiotic therapy while awaiting laboratory results (e.g., CBC, blood culture). [1]
Management [1][39][40]
- Start IV fluid therapy as needed; avoid overhydration.
- Start empiric antibiotic therapy (see below) parenterally while awaiting diagnostic results. [1]
- While patients are receiving broad-spectrum antibiotics, hold prophylactic penicillin.
- Evaluate for and treat any underlying conditions; see relevant articles for details, e.g.:
- Sepsis
- Meningitis
- Pneumonia: should be managed as acute chest syndrome [34]
- Septic arthritis
- Osteomyelitis (especially Salmonella, Staphylococcus aureus)
- Acute cholecystitis (secondary to cholelithiasis, choledocholithiasis)
Disposition [1][41]
- Admit patients for IV antibiotics if any of the following conditions are met:
- Age < 12 months
- Ill-appearing
- Laboratory results concerning for serious bacterial infection
- New hypoxia or saturation < 3% from baseline
- Temperature 39.5°C (≥ 103.1°F)
- Not tolerating enteral feeds
- Social factors affecting ability to seek care
Empiric antibiotic therapy
- Coverage: typically against S. pneumoniae and gram-negative enteric organisms [1]
- First-line: IV third-generation cephalosporin (e.g., ceftriaxone: ) [42][43]
- Second-line (e.g., due to allergy): clindamycin [39]
- Suspected acute chest syndrome: Add azithromycin. [1]
-
Severe illness or suspected meningitis [39][40][42][44]
- Increase dose of ceftriaxone.
- Add vancomycin.
Contraception and reproductive counseling [1]
- Educate both men and women with sickle cell disease or trait on contraceptive information; see “Family planning” and “Contraception” for details.
-
Contraception options for patients with sickle cell disease:
- Barrier contraception
- Progestin-only contraceptives
- Levonorgestrel-releasing intrauterine device
- Vasectomy, tubal sterilization
Preconception counseling [1]
- Counsel patients and their partners that pregnancy in women with sickle cell disease is considered high risk.
- Screen reproductive partners of patients with sickle cell disease or trait for hemoglobinopathy.
- Patients desiring to have children should be offered genetic counseling and prenatal folic acid supplementation.
Sickle cell disease in pregnancy [45]
-
Maternal complications [1][46]
- Anemia (most common)
- Increased risk of sickle cell crisis, infections (e.g., sepsis, pneumonia, UTIs), preeclampsia, and thrombotic complications (e.g., cerebral thrombosis, deep vein thrombosis)
- Increased perinatal mortality and necessity of blood transfusions
- Fetal complications: increased risk of fetal growth restriction, low birth weight, preterm delivery, and stillbirth [1]
-
Management [1][45]
- Close maternal and fetal surveillance by experienced health care personnel (e.g., maternal-fetal specialists, sickle cell experts, and experienced obstetricians)
- Hemoglobin levels should be measured monthly.
- Evaluate the need for VTE prophylaxis and transfusion therapy in consultation with a sickle cell expert.
- Management of vasoocclusive crises and events
- Analogous to management in nonpregnant individuals.
- Avoid NSAIDs (see “Overview of analgesics to avoid during pregnancy” for details).
- The safety of hydroxyurea therapy during pregnancy and breastfeeding has not been established. [1][19]
Recurrent vascular occlusion and disseminated infarctions lead to progressive organ damage and loss of function. In homozygotes, this progress is associated with high morbidity and mortality. In heterozygotes, organ damage is very rare.
Acute complications
| Acute complications of sickle cell disease [1] | |
|---|---|
| Possible complications | |
| Hypotension and/or tachycardia |
|
| Neurologic changes |
|
| Severe pain |
|
| Abdominal pain |
|
| Respiratory symptoms |
|
| Acute anemia [1] |
|
| Fever |
|
| Renal symptoms |
|
| Ocular symptoms |
|
Patients with sickle cell disease have increased renal tubular secretion of creatinine, so acute renal failure may be present even if creatinine is in the normal range. [1]
Chronic complications
| Chronic complications of sickle cell disease [1] | |
|---|---|
| Organ system | Complications |
| Spleen |
|
| Kidney |
|
| Skeletal |
|
| CNS |
|
| Lungs |
|
| Heart |
|
| Liver |
|
| Treatment-related complications |
|
As a result of repeated infarction of the spleen in sickle cell patients, the spleen is often atrophied rather than enlarged!
We list the most important complications. The selection is not exhaustive.
- Individuals with sickle cell trait are less likely to develop severe forms of malaria and have reduced parasiteprevalence. [50]
- The exact mechanism of malaria resistance is unknown; presumably, the plasmodia responsible for malaria are unable to multiply sufficiently within the erythrocytes and some studies suggest increased sickling in infected RBCs.
- One-Minute Telegram 17-2021-1/3: A CRISPR-Cas miracle? Report on two successful attempts at treatment
Interested in the newest medical research, distilled down to just one minute? Sign up for the One-Minute Telegram in “Tips and links” below.